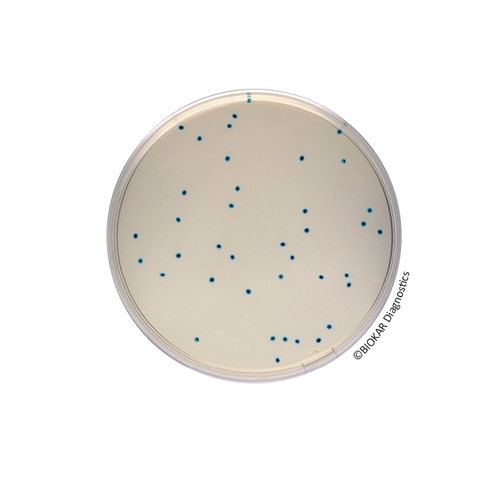
COMPASS® Enterococcus Agar

COMPASS® Enterococcus Agar
COMPASS® Enterococcus Agar is a selective media used for the enumeration of enterococci in food and water.
| Ürün Adı | COMPASS® Enterococcus Agar |
| Ürün Kodu | BK183HA |
| Miktar | 500 g |
| Ürün Adı | COMPASS® Enterococcus Agar |
| Ürün Kodu | BM11608 |
| Miktar | 10 vials of 100 mL |
| Ürün Adı | COMPASS® Enterococcus Agar |
| Ürün Kodu | BM15708 |
| Miktar | 20 Petri plates Ø 55 mm |